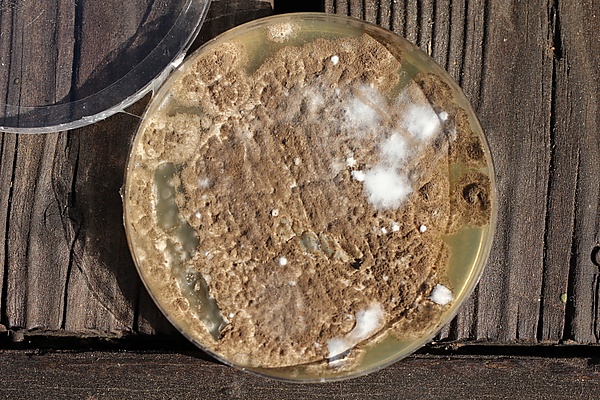

Пеницилл коротко-компактный
Пеници́лл (пеници́ллий) ко́ротко-компа́ктный (лат. Penicíllium brevicompáctum) — вид несовершенных грибов (телеоморфная стадия неизвестна), относящийся к роду Пеницилл (Penicillium).
Ксерофильный вид, определяемый по ограниченно растущим колониям и довольно крупным, но очень компактным трёхъярусным кисточкам конидиеносцев.
Общие сведения
| Пеницилл коротко-компактный | |
|---|---|
| Научная классификация | |
|
Домен: Царство: Подцарство: Отдел: Подотдел: Класс: Подкласс: Порядок: Семейство: Род: Подрод: Секция: Вид: Пеницилл коротко-компактный |
|
| Международное научное название | |
| Penicillium brevicompactum Dierckx, 1901 |
Описание
Колонии на агаре Чапека ограниченно растущие, за 7 дней достигают диаметра в 1—1,5 см, бархатистые, спороношение среднеобильное или обильное, серо-зелёное до жёлто-зелёного. Реверс светлый или красновато-коричневый, экссудата обычно нет или же он бесцветный, необильный. На CYA растут быстрее, достигая 2—3 см за неделю, радиально складчатые, менее активно спороносящие, часто с коричневатым экссудатом, нередко скрытым в плотном мицелии. Реверс желтоватый, красновато-коричневый, реже светлый; часто выделяется красно-коричневый растворимый пигмент. Колонии на агаре с солодовым экстрактом (MEA) ограниченнорастущие — до 2 см в диаметре на 7 сутки, плоские, реже складчатые, бархатистые, спороношение среднеобильное до обильного, тёмно-зелёное, реже с голубоватым оттенком или более светлое. Реверс светлый, жёлто-коричневый или красно-коричневый. При 37 °C рост отсутствует.
Конидиеносцы трёхъярусные, гладкостенные, 300—800 мкм длиной и 4—6 мкм толщиной, с плотно прижатыми короткими элементами, отчего сами кисточки (от первого разветвления до кончиков фиалид) нередко более короткие, чем широкие (расстояние между крайними фиалидами). Метулы цилиндрические, со вздутием на верхушке, 10—15 мкм длиной. Фиалиды цилиндрические, постепенно суженные в шейку, 8—15 × 2,5—4,5 мкм. Конидии эллипсоидальные, едва шероховатые, 2,5—3,5 × 2—2,5 мкм.
Определяется по коротким веточкам и метулам со вздутиями на верхушке, собранным в компактные вееровидные кисточки, краевые фиалиды которых часто направлены почти в противоположные стороны.
Наиболее близкий вид — Penicillium bialowiezense, отличающийся более короткими и менее толстыми конидиеносцами. Синтезирует хинолактацин A (P. brevicompactum синтезирует бревианамид A).
Экология и значение
Компонент почв хвойных лесов, обрабатываемых почв, встречается на самых разнообразных пищевых продуктах и отходах. Отмечается на плодовых телах агарикоидных грибов — Amanita citrina, Boletus, Flammulina velutipes, Paxillus involutus, Pleurotus ostreatus и других, также — на древесине, на косметических продуктах.
Один из наиболее ксерофильных пенициллов, способен прорастать и расти при aw = 0,78.
Продуцент микофеноловой кислоты — антибиотика, противоопухолевого и иммунодепрессантного вещества. Некоторые штаммы синтезируют токсичный ботриодиплоидин.
Таксономия
Penicillium brevicompactum Dierckx, Ann. Soc. Sci. Bruxelles 25 (1): 88 Архивная копия от 13 сентября 2018 на Wayback Machine (1901).
Примечания
Литература
- Frisvad J., Samson R. A. Polyphasic taxonomy of Penicillium subgenus Penicillium. A guide to identification of food and air-borne terverticillate Penicillia and their mycotoxins // Studies in Mycology. — 2004. — Vol. 49. — P. 64.
- Kozakiewicz Z. Penicillium brevicompactum // IMI Descriptions of Fungi and Bacteria. — 1992. — Vol. 1102. — P. 1—2.
- Samson R. A., Hoekstra E. S., Frisvad J. C. Introduction to food- and airborne fungi. — 2004. — P. 190.